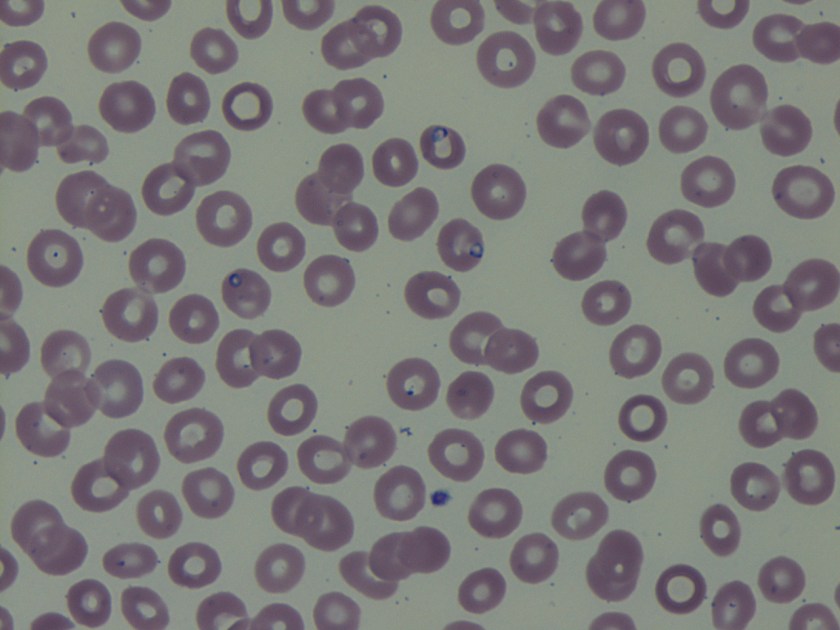
babesia

Case History
A 68 year old man presents with complaints of generalized weakness that started 3 weeks after his trip to the United Kingdom. The patient endorses night sweats, myalgia, fever, headaches, decreased appetite, mild nausea but no vomiting or diarrhea. He denied any history of recent rashes or arthralgia. The patient lives in a tick endemic area in the Northeastern part of the United States. Approximately 2 months ago he noticed an engorged tick while in the shower for which he completed a prophylactic course of doxycycline. He has sufficient titers for Lyme antibody; however no antibodies were present for Anaplasma. Blood smears were ordered for review.
Lab Identification
On the thin blood smears, there were multiple vacuolated, pleomorphic, ring-form like organisms seen in multiple infected red blood cells. No extracellular organisms were identified.
The organism was identified as a species of Babesia with 0.8% parasitemia and confirmed by PCR as Babesia microti.
Discussion
Babesia species are infectious protozoa which infect and cause lysis of red blood cells. Symptoms develop over the course of weeks to months and vary in severity. The most common symptoms are nonspecific flu-like symptoms (e.g., fever, chills, body aches, weakness, fatigue). If left untreated patients can develop hemolytic anemia, thrombocytopenia, disseminated intravascular coagulation, hemodynamic instability, and possibly death.1
The main agents of human babesiosis are B. microti in the northeastern and upper midwestern regions of the United States, B. duncani in the western regions of the United States, and B. divergens in Europe. Occasionally on blood smears Babesia parasites can be difficult to differentiate from Plasmodium falciparum; Babesia species however are pleomorphic, vacuolated, and can appear inside red blood cells or outside red blood cells whereas Plasmodium falciparum are typically only seen inside red blood cells.1 In most cases the diagnosis for babesiosis can be made on the basis of morphological features on thick and thin smears. However, for patients with subclinical symptoms, very low parasitemia with undetectable organisms on blood smears and a high clinical suspicion for babesiosis serologic and molecular testing can be offered. Serologic testing has 88-96% sensitivity and 100% specificity in patients with no concurrent history of malarial infections. There is some possibility of cross-reactions in serum specimens in patients with malarial infections.2 Molecular techniques such as PCR are excellent tools for the purposes of screening and in addition can help to differentiate amongst the different variants of Babesia species.3 As in this case PCR was used to rule out possible infection with B. divergens due to the patient’s recent travel history to the United Kingdom. The two major antimicrobial regimens for babesiosis are atovaquone plus azithromycin for mild infection or quinine plus clindamycin for more severe infections.1
References
- Resources for Health Professionals. (2013, July 19). Retrieved August 21, 2017, from https://www.cdc.gov/parasites/babesiosis/health_professionals/index.html#dx
- Krause PJ, Telford S RI, Ryan R, et al. Diagnosis of babesiosis: Evaluation of a serologic test for the detection of Babesia microti J Infect Dis 1994;169:923-926.
- Hojgaard A, Lukacik G, Piesman J. Detection of Borrelia burgdorferi, Anaplasma phagocytophilumand Babesia microti, with two different multiplex PCR assays. Ticks and Tick-borne Diseases 2014 (5):349–351.
-Noman Javed, MD is a 1st year anatomic and clinical pathology resident at the University of Vermont Medical Center.

-Christi Wojewoda, MD, is the Director of Clinical Microbiology at the University of Vermont Medical Center and an Associate Professor at the University of Vermont.
It’s interesting but not found here in our country. I just saw it in a sample received from CAP for our laboratory proficiency testing….